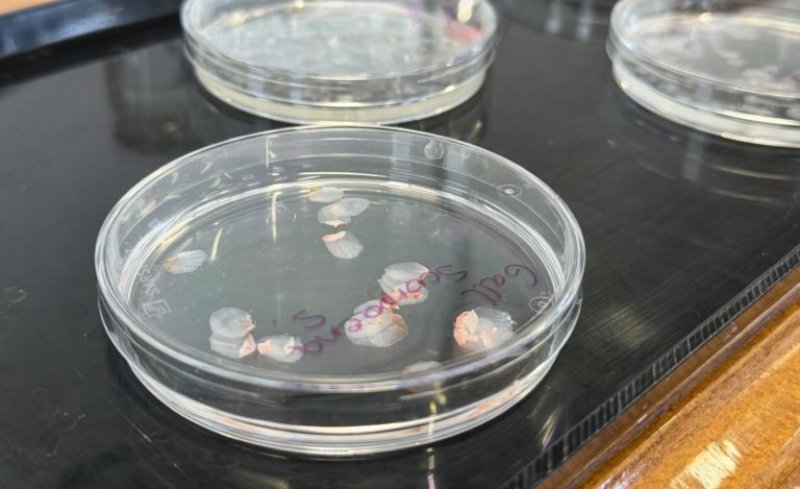

西班牙格拉納達大學研究團隊以市售鯉魚等魚類鱗片為原料,研發出具備高度生物相容性且透明堅韌人工角膜植入物。研究團隊透過實驗室及動物實驗,確認植入物角膜修復再生功能良好,期望能減少角膜移植對捐贈者依賴並提供低成本醫療方案。
魚鱗結構適合角膜修復
組織工程小組 ibs.GRANADA 及格拉納達大學主導這項研究。研究團隊全面分析魚鱗結構,發現魚鱗非常適合用於角膜修復。團隊處理常見魚類鱗片,製作成具備高度生物相容且透明堅韌的植入物。
提供低成本角膜移植方案
原本角膜缺乏血管及再生能力,使得嚴重角膜疾病極難修復,患者大多需要接受角膜移植,但捐贈者短缺。Ingrid Garzón 教授指出這種材料容易取得且價格低廉,同時也促進格拉納達漁業發展。
Miguel Alaminos 教授強調開發不依賴捐贈者的再生方法至關重要。雖研究已獲得良好動物實驗結果,團隊仍需要進行人體試驗方可做臨床應用。
研究團隊已於國際學術期刊發表相關研究結果。
- Fish scales, a revolutionary solution for regenerating the human cornea
- Spanish researchers develop low-cost artificial cornea from fish scales
(本文由 Unwire HK 授權轉載;首圖來源:ibs.GRANADA)










